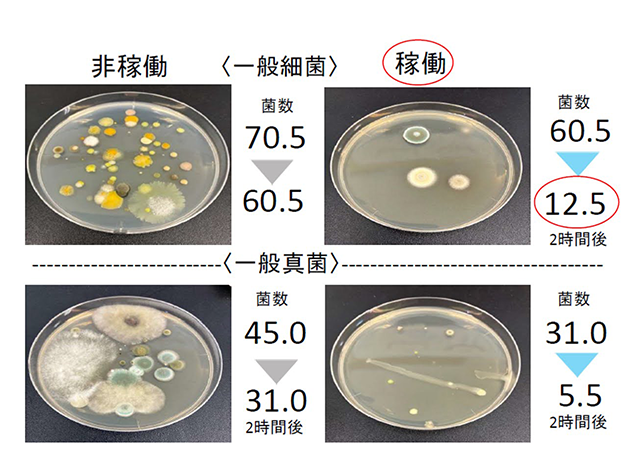

エア・ウォーターLINE株式会社
事業内容
青果物流事業
長年の信頼と経験で培った、お客様のニーズに柔軟に対応する効率的で高品質な青果物流。
生産者の手元から食卓に届くまで、新鮮なままに青果をお届けする物流サービスを提供します。
鮮度保持技術
専門機関と共に研究を重ね、複数の技術を組み合わせて作り上げた、青果の鮮度を保ったまま運ぶ新しい流通の形。コールドチェーンを含めた、産地から食卓まで続くシームレスな鮮度保持流通で、産地の恵みを新鮮なままお届けします。
- 青果の鮮度保持において重要な水分保持と細菌の不活性化を実現
- 青果品目ごとの最適な温度・湿度管理およびエチレンガス対策
- 産地倉庫から輸送トラック、消費地倉庫まで、通過する各ポイントに鮮度保持装置を設置
- 鮮度保持によりロス(廃棄)を軽減し商品の歩留まりを向上

共同配送
トラック1台に満たない複数荷主の小ロットの商品を混載する共同配送により、物流を効率化。生産地からの幹線輸送をはじめ、関西エリアを中心としたスーパーマーケットの物流センター向けの配送など、長年の実績によって作り上げたネットワークにより幅広く柔軟に対応し、最適な輸送を提案します。
- 産地から消費地に向けた共同幹線輸送
- 多品種小ロットに柔軟に対応し、輸送コストを抑制
- 関西エリアを中心に、60件以上のスーパーマーケット物流センター、市場に配送



センター運営
大生産地である熊本で2023年に竣工した熊本低温物流センターと、関西消費地エリアをカバーする京都低温物流センターを運営。生産者から卸売会社、仲卸会社から量販店まで、各地域のお客様の希望に合わせ、温度管理や鮮度保持保管から、納品時間に合わせた柔軟な出荷・配送など、幅広いニーズにお応えします。
- 複数温度帯による青果品目ごとの最適な温度管理
- 365日24時間稼働(京都低温物流センター)でニーズに合った柔軟なサービスを提供
- 複数の市場や産地から入荷する商品の共同配送・中継輸送



青果市場内物流
卸売市場の荷受業務、場内配送などの市場内物流を一括して受託。長年の実績で培ったノウハウを活かし、オペレーションの見直しや管理体制の強化で待機時間を削減し、効率的な現場運営と整った市場環境づくりをサポートします。
- ノウハウを活かした市場内物流の最適化
- ルールの明確化と運用による待機時間の削減



流通サポート事業
温度管理の不可欠な食品物流から、青果の袋詰めなどの流通加工まで。
長年の経験で培ったノウハウにより、流通に関わる様々な業務をきめ細かくサポートします。
流通加工
一般貨物を扱う大阪物流センターで大手住宅メーカーの水回り壁材のシュリンク梱包を行っています。青果を扱う京都低温物流センターでは、青果流通において欠かすことのできないパック詰めや袋詰めなどの流通加工を行っています。
効率的な物流と丁寧な作業を組み合わせることで、 商品価値をさらに高める流通加工を提供します。
- パネル材をシュリンク梱包し、発注数に合わせてピッキング
- 青果加工専門企業と連携した青果のリパックやカミサリー業務



食品物流
チルド・フローズンなど、複数の温度管理の必要な乳製品から、大手メーカーの加工食品まで、食品全般の保管・輸送を受託し、お客様の事業を支える物流サービスを提供します。
輸送効率化から、センターでの受注対応、正確な在庫管理、突発的なオーダーへの柔軟な対応まで、専門スタッフによる徹底した品質管理で、大切な商品を迅速かつ確実にお届けします。
- 大手塩製造会社(グループ会社)塩製造工場内での保管、ピッキングと、食品工場で使用する原料や塩製品の全国への輸送
- 大手乳製品メーカー 受注業務から、常温・チルド・フローズンでの倉庫保管、ピッキング、輸送までの一貫した物流を受託
- 大手パックご飯製造会社 WMS(倉庫管理システム)、電動式ラックを備えた物流センターでの保管・ピッキングと全国への商品輸送



運送事業
西日本エリアを中心としたメーカー物流から、北海道・東日本と連携したシャーシ輸送、高度な温度管理が必要となる医療輸送まで、幅広く事業を展開。倉庫事業においては、三重県亀山市に常温・チルド・フローズンの3温度帯倉庫と危険物倉庫を構え、様々なニーズに合わせたサービスを提案します。
一般貨物輸送
中部、関西、中四国、九州まで西日本の各エリアに21の拠点を配置。地域に密着した配送網と拠点間の幹線輸送により、西日本全域の輸送ネットワークを確立。
大手住宅関連機器のメーカー輸送など多数の実績があります。西脇荷捌きセンターでは工場で生産される製品の出荷量変動に対応するため、約12,000坪の面積を活かし、ロットの大小にかかわらず積載率を追究した輸送をご提案します。
- 関西~九州・中部・関東間の幹線輸送
- 工場間配送、幹線・支線輸送などのメーカー物流
- 大手家電メーカー・機械メーカーの荷捌き場として業務を受託



シャーシ事業
フェリーを活用したシャーシ(海上コンテナ)輸送を九州~本州間で展開しています。また、北海道・東日本を事業領域とするグループ企業のエア・ウォーター物流と連携し、北海道~本州間の輸送も行います。シャーシによる大量輸送により物流コストを削減し、モーダルシフトによるCO2削減で環境負荷を軽減します。
- 九州、関西のシャーシ拠点とエア・ウォーター物流との連携による全国規模のシャーシ輸送
- 大量輸送による物流コストの削減
- モーダルシフトによるCO2の削減、ドライバーの労働時間の削減。



倉庫事業
3温度帯(常温、チルド、フローズン)倉庫と危険物倉庫を持つ多機能型の亀山物流センター。商品の保管から在庫管理、出荷まで、一貫したサポートを実現します。同センターはシャーシ輸送事業の拠点でもあり、保管から輸送を含めたトータルサービスをご提案します。
- 亀山物流センター:ドラッグストアのチルド商品日配センター/半導体メーカーの危険物倉庫保管



調達物流・販売物流
1台のトラックが数か所を回るミルクラン方式により、複数のサプライヤーから様々な部品商材を集荷。物流センターで集約した部品商材を各地域の工場へ幹線輸送します。小ロットの荷物をまとめて集荷・配送することで、車両台数を削減し、物流コストを削減します。工場から各地域の拠点、そこから納品先まで製品を運ぶ販売物流も行い、調達から販売までのバリューチェーン構築をサポートします。
調達物流・販売物流
フロー図


医療輸送
血漿分画製剤用の原料血漿の輸送の他、原料血液、輸血用血液など、血液に関する輸送を受託。エア・ウォーターグループの開発したクーリングコンテナによってマイナス20度以下を保ち続ける厳格な温度管理を行い、命に関わる大切な輸送に携わっています。
- 原料血漿等の血液に関する輸送
- クーリングコンテナによるシームレスな温度管理



機械輸送・搬入および設置
大手回転寿司チェーンのレーンや工場の製造ラインなど、機械搬入・設置を受託。お客様の事業展開に支障がでないよう工期を厳守し、どのような現場でも安定した水準で作業を実施。多数の実績で培ったノウハウにより、お客様の要望に合わせた柔軟なサービスを提供します。
輸送においては、ウイング車や平ボデー等、複数の車種を所有し、精密機器、工場の製造ライン機器、大型プラントなど、様々な形状や大きさの商品に幅広く対応します。
- 回転寿司、焼き肉店のレーン輸送・設置・解体
- 食品工場などの製造ラインの輸送・設置
- 業務用冷蔵庫、ショーケースの輸送・設置
- 大型プラント輸送・設置工事



車両開発事業
グループ会社の北海道車体と連携した、オーダーメイドでのトラックボディの開発・製造。鮮度保持装置を搭載した鮮度保持トラックの開発。
車両の独自開発により、大切な商品を、より適切に、鮮度を保ったままお客様の元までお届けします。
北海道車体と連携した車両開発
消防水槽車や動物運搬車などの特殊ボデーなど、様々な開発実績のあるグループ会社の北海道車体株式会社と連携し、オーダーメイドで車両を開発。車両開発から始まる新しい物流を提案します。



鮮度保持トラックの開発・提案
青果物の鮮度保持と細菌抑制の2つの技術を組み合わせて搭載した、鮮度保持トラックを開発。 産地や消費地の物流施設だけでなく、輸送中も常に鮮度を保持し、途切れることのない鮮度保持物流を実現します。



